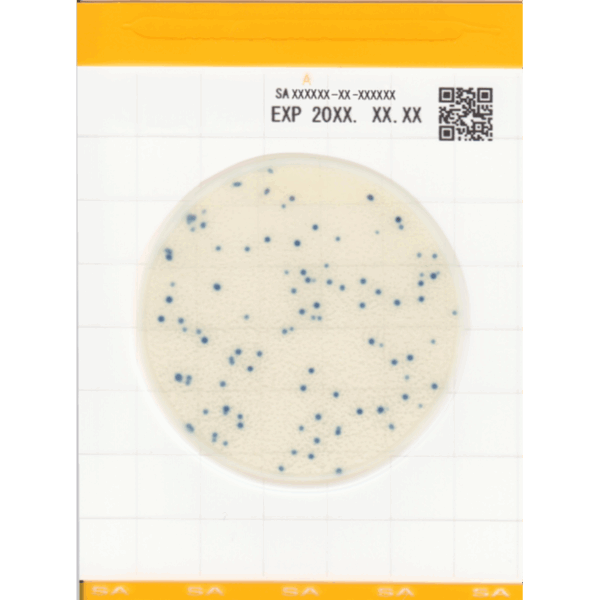
Labset Easy Plate SA_Staph aureus Labset Easy Plate SA_Staph aureus
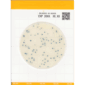
Labset Easy Plate SA_Staph aureus

Easy Plate SA Staphylococcus aureus
49,70 € (preço sem IVA)
Disponível por encomenda
CompararVantagens Labset:
- Garantia de confiança
- Produtos selecionados
- Envio em 48h
Para identificação de Staphylococcus aureus em produtos alimentares.
- Operação simples.
- Resultados fiáveis.
- Certificado AOAC.
- Alta precisão.
- Pronto a utilizar, coloque uma suspensão de amostra na placa e inicie a incubação.
- Menos espaço de incubação e desperdício reduzido.
O Easy Plate SA é um dispositivo de cultura microbiológica composto por uma folha impermeável, um meio seco pronto sobre a folha e uma cobertura transparente sobre o meio.
O método Easy Plate SA recebeu a certificação SM (111703) do Instituto de Investigação AOAC para onze matrizes alimentares: carne de vaca moída crua, carne de borrego crua, presunto cozido, salmão cru, camarão congelado, massa fresca refrigerada, leite pasteurizado, queijo natural, profiterole e salada de batata.
Durante a preparação das placas para incubação, não são necessárias ferramentas adicionais. Isto deve-se ao anel hidrofóbico em redor da área de cultura, que auxilia na dispersão automática da amostra na área de cultura.
Utilização:
Prepare a amostra de acordo com o manual. Em seguida, coloque 1 ml da solução da amostra numa pipeta e, depois, abra a tampa da placa. Logo após, pipete cuidadosamente a solução da amostra para a placa e, por fim, feche a tampa. Por último, incube conforme as instruções do manual.
Vídeo de demonstração: clique aqui
| Microrganismos alvo | Staphylococcus aureus |
|---|---|
| Incubação | 24 horas (±1 hora) |
| Temperatura de incubação | 35 ºC (±1 ºC); 37 °C (±1 ºC) |
| Conservação | 2 a 8 ºC |
| Prazo de validade | 18 meses após produção |
| Embalagem | 25 Testes |
Apenas clientes com sessão iniciada que compraram este produto podem deixar opinião.
Ficheiros disponíveis (apenas para clientes registados).

Avaliações
Ainda não existem avaliações.